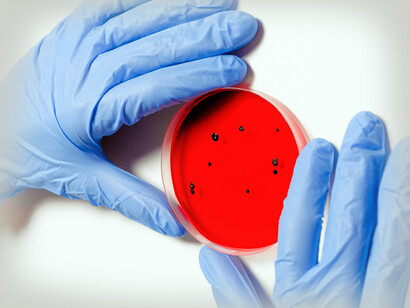
La ciencia juega un papel fundamental en el desarrollo social y económico de la humanidad

Al presente, es absolutamente válido afirmar que la ciencia ha dado lugar a la tecnología, desde las cavernas con la aparición del empleo del fuego y luego la rueda, hasta llegar a internet y la inteligencia artificial en el siglo XXI; desde la escritura en tabletas de barro a escribir en los papiros, pasando por la invención de la imprenta para difundir el conocimiento… la tecnología es la base que alimenta la industria, el comercio, la información, la construcción, la educación, la medicina, etc. Todo ello constituye una clave fundamental del progreso humano y la cultura universal.
Hace 50 mil años, nuestros antepasados los cazadores y labradores inventaron las técnicas de cacería y labranza; con ello permitieron a las tribus humanas asentarse y proliferar al obtener más fácilmente medios para alimentarse. Con eso se lograban mejores oportunidades para interacciones sociales, creándose, de este modo, el principio de la sociedad organizada y el inicio de la civilización. La ciencia primitiva había entonces colocado sus primeros ladrillos.
El ser humano a través de la historia ha tratado de buscar “la verdad” en los hechos de la naturaleza. Lo anterior se debe, en parte a su curiosidad, una cualidad especial de los animales superiores, muy desarrollada en los humanos. Desde que nace, el niño se convierte en un descubridor natural, comienza a reconocer la voz de su madre (ya escuchada por el feto en el interior de la matriz antes de nacer), su contacto con ella le da seguridad, continúa con los alimentos complementarios, luego lo existente en el medio donde lo sitúan, los sonidos que escucha, los sabores de lo que le ofrecen y posteriormente los colores, distingue ya a las personas y los animales, etc.; en realidad el niño desde que nace indaga para comprender. Es por eso que luego el ser humano busca entender por qué suceden las cosas e investiga entonces para comprender la verdadera causa de los fenómenos. Para lograr esto inventó la ciencia, como producto de su privilegiada mente, para que el descubrimiento científico supuestamente le informara, en última instancia de la naturaleza de las cosas que le rodeaban o de los hechos que lo afectaban.
La ciencia surgió de la observación de los fenómenos y de la explicación que algunas mentes privilegiadas de la antigüedad como Tales, Heráclito, Demócrito, Hipócrates, Aristóteles, etc., dieron a estos. Fenómenos que en esas épocas eran achacados a los diversos dioses o divinidades en que cada pueblo creía. Con el transcurrir del tiempo y al ver los humanos que diversas explicaciones o teorías que se habían dado para explicar un fenómeno eran sustituidas en el tiempo por otra más efectiva, se dieron cuenta de que no existen “verdades absolutas o últimas”, por lo que entonces asombra saber que la misma ciencia, el progreso humano y la civilización han sido logrados con “verdades relativas” y además, se dieron cuenta de una verdad y es que, “la ciencia no tiene respuesta para todo”.
En las diversas naciones que conforman nuestro mundo existen costumbres, modas, ideologías, religiones, alimentos y lenguas muy diferentes, e incluso, muchos de los valores morales, religiosos y estéticos son distintos según países y épocas. Pero la ciencia es igual en todo lado, con excepción del grado de su desarrollo. Al momento podemos decir que universalmente existe unidad en la ciencia, pero pluralidad en las culturas. Pero, debemos aclarar que no existe una ciencia norteamericana, china, rusa, inglesa o mexicana. Existe una única ciencia, pero el grado del avance de esta está en relación con la capacidad económica y de recursos que se poseen para desarrollarla y crear tecnologías que tienen diversos usos. Lamentablemente lo anterior es causa de un desarrollo humano diferente pues los países pobres no tienen capacidad de crear la misma tecnología, lo que acentúa las diferencias.
La ciencia ha entrado entonces a jugar un papel fundamental en el desarrollo social y económico de la humanidad. Ante el fracaso de las ideologías para dirigir el mundo y la aparente pérdida de poder de las religiones (aunque algunas como la del islam han continuado creciendo), la ciencia y la tecnología, junto con la expansión de la información y la educación, se están perfilando como las fuerzas generales que más parecen influir en el ser humano en estos momentos. A esas dos corrientes directoras de nuestro tiempo hay que agregar el proceso económico, ya que problemas de esta índole en un país o área geográfica inciden notablemente en los cambios y trasformaciones de los pueblos. Si la economía es estable, los cambios tienen más posibilidades de desarrollarse en forma positiva, pero suelen detenerse o dar lugar a una crisis político-social si la economía está mal. Ni la ciencia, la política, la religión o la educación escapan en muchos sentidos a los problemas de los recursos económicos de un país.
Pero, parece existir unanimidad en aceptar que la ciencia, bien conducida, se convierte en una fuente privilegiada de cambio, no solo tecnológico y económico sino también social. La esperanza es que, en el futuro, ese desarrollo sirva para lograr el progresos humano y no sea un elemento de guerra y destrucción, ya que no falta quien la califique –y no sin cierta razón– de ser, en muchos aspectos, la responsable de una posible declinación de la humanidad debido a la contribución al descubrimiento del petróleo y la gasolina, que han contaminado al atmosfera y los ríos, agravando el cambio climático o su participación en la creación de armas nucleares cuyo empleo puede ocasionar la desaparición de la vida de los seres humanos del planeta Tierra.
El problema es que la ciencia no es buena ni mala, simplemente es. Aunque el hombre debería utilizarla para lograr un mejor desarrollo humano, no es posible encontrar en la ciencia este fin, pues el hombre puede emplearla para fines buenos o malos, en razón de ser él quien establece en qué emplea cada descubrimiento científico. Podríamos decir sin temor a equivocarnos que la finalidad real de la ciencia es mejorar el conocimiento humano, de tal manera que las contradicciones que frecuentemente existen en cuanto a los hechos o las cosas puedan ser aclaradas.
Aunque la ciencia puede ayudarnos a lograr un mundo mejor, la búsqueda de una sociedad armoniosa y perfecta es una utopía; de hecho, lograr esto es imposible, ya que no se puede pretender una sociedad perfecta, constituida por una colección de seres o almas diferentes e imperfectas como las existentes. No podemos pedir entonces a la ciencia algo imposible.
Estamos llegando a un grado tal de complejidad de la ciencia que hemos inventado, que se están creando grandes paradojas en ella como aceptar que antes de la llamada Gran Explosión o Big Bang, momento en que se originó la materia, la energía, la luz, el espacio y el tiempo, dando lugar al Universo, no había nada. Entender eso es muy difícil ya que, si no había nada, cómo se produjo todo lo anterior, y aunque se nos diga que se cree que antes existían campos cuánticos, la verdad es que aceptar que de la nada surgieron las estrellas, los planetas, la luz, en fin, el Cosmos como lo conocemos, eso es un problema de gran complejidad para la mente. Sobre todo, si aceptamos el principio de la causalidad, o sea, que todo efecto tiene su causa, en lo que se basa la teoría de la gravedad de Newton y la relatividad de Einstein ya comprobados muchas veces para efectos del cosmos y el mundo que nos rige.
Y luego nos señalan que el principio de la causalidad está en contraposición con las leyes que rigen el microcosmos o mundo subatómico. Ahí no sirve la causalidad y en cambio el azar tiene su lugar. Entender esto es muy difícil, ya que la teoría cuántica reconoce que los constituyentes últimos de la materia son al mismo tiempo sustancia y no sustancia. Vemos pues que la ciencia está llena de paradojas.
El Homo Faber, ese ser con inteligencia superior producto de la evolución y que, gracias a su inteligencia, creó la ciencia, tiene al parecer como fin trasformar el mundo que lo rodea; y como siempre aspira a más, en la actualidad está la ciencia siguiendo dos caminos, o más bien dos aventuras. La primera se dirige a tratar de conocer al ser humano en su interior, para comprender los aspectos psíquicos que rigen su vida y, además, guía sus pasos hacia conocer el medio ambiente que le rodea, donde se desenvuelve y del cual depende para sobrevivir. La segunda aventura va hacia lo desconocido, rumbo a las estrellas, buscando conocer el Universo no tanto en su totalidad lo cual es imposible, sino investigar la posibilidad de vida inteligente en otras áreas del cosmos. Esos son los dos más grandes retos del futuro de la ciencia.
Habiendo el filósofo Jenofonte propuesto al Oráculo de Delfos le señalara
quién era el hombre más sabio de la época. La sacerdotisa respondió que
el hombre más sabio era Sócrates.
Éste al escuchar eso señaló que, él había sido escogido como el más sabio
solo “porque sabía que no sabía”
Sócrates sentó así las bases del carácter no absoluto del saber, fundamento
de la única y verdadera ciencia.